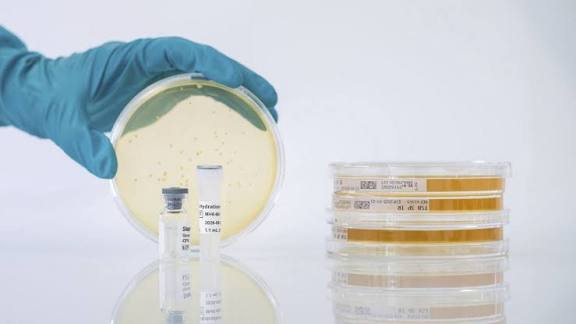
سلالات رقابة الجودة (QC Strains) في المختبرات الميكروبيولوجية سلالات رقابة الجودة (QC Strains) في المختبرات الميكروبيولوجية

سلالات رقابة الجودة (QC Strains) في المختبرات الميكروبيولوجية
في صناعة الأدوية، تمثل سلالات الجودة (QC strains) جزءًا أساسيًا من النظام المعتمد لضمان سلامة وفعالية المنتجات. يُوصى بشدة بالحفاظ على سجل سلالات (strain logbook) الذي يوثق معلومات حيوية مثل معرف السلالة المرجعية (Reference strain ID)، ورقم الجيل أو عدد التمريرات (Generation / passage number)، وتاريخ إعادة التشكيل (Date of reconstitution)، وظروف التخزين (Storage conditions)، وتاريخ انتهاء صلاحية (Expiry of working culture).
كما يجب تسجيل الملاحظات (observations) بشكل دوري، حيث يُعتبر السجل بمثابة دفتر يوميات للسلالة. المبدأ الرئيسي هو أن سلالات الجودة جزء لا يتجزأ من النظام المعتمد، وفقدان سلامة السلالة يعني فقدان صلاحية الاختبار (Loss of strain integrity = Loss of test validity).
هذا يتوافق مع اللوائح الصيدلانية مثل USP-NF <61> للفحص الميكروبيولوجي للمنتجات غير المعقمة، و<62> لاختبارات الكائنات الدقيقة المحددة، بالإضافة إلى CLSI M07 لاختبار حساسية المضادات الحيوية، وEU GMP Annex 1 المتعلق بمبادئ السيطرة الميكروبيولوجية.
من ناحية أخرى، يتطلب التحكم في دورة حياة السلالة وإجراءات الاختبار دقة عالية. معظم سلالات الجودة مستقرة لمدة تصل إلى 4 أسابيع، لكن الكائنات سريعة النمو (Fastidious organisms) تحتاج إلى تمرير فرعي متكرر، وبعد الأسبوع الرابع يجب التخلص من السلالات والبدء من حبيبات مجففة جديدة (lyophilized pellet)، مع تبرير ذلك بناءً على تقييم مخاطر GMP. أما احتياطات الاختبار فتشمل عدم الاختبار مباشرة من لوحة الحبيبات الأصلية، واستخدام مستعمرات معزولة فقط، وتفضيل سلالات لا تتجاوز 24 ساعة للاختبارات الكيميائية الحيوية، مع مراقبة استقرار مقاومة المضادات الحيوية. من منظور GMP والمفتشين، يُتوقع وجود دورة حياة محددة للسلالة، وعدد تمريرات محدد، وتتبع كامل للمرجعية، حيث يُعد الحفاظ على السلالات جزءًا من سلامة البيانات. يُفضل عمل تمريرات من السلالة المرجعية على شكل الجيل الأول، ثم الثاني، وأحيانًا الثالث فقط.